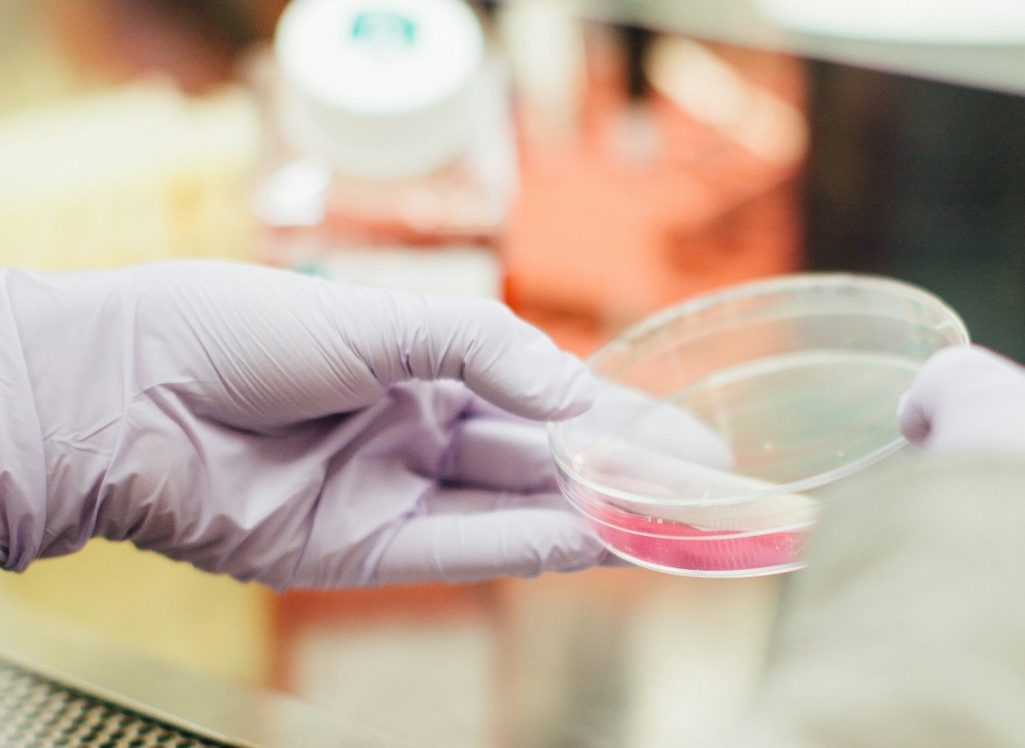

Your Trusted Partner in Health
Get to Know Us!
At Bluebell Health Services, we believe in a holistic approach to healthcare.
We are passionate about prioritizing patient well-being
and ensuring you receive comprehensive care
tailored to your unique needs.